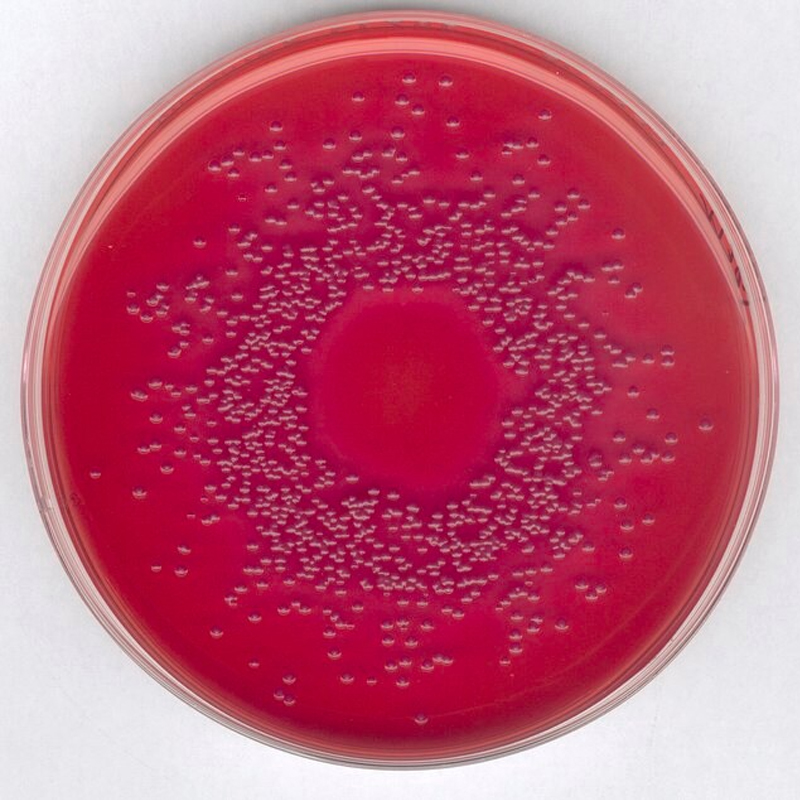
默克Merck 麦康凯琼脂培养基 (MCA)  1.00205.0500
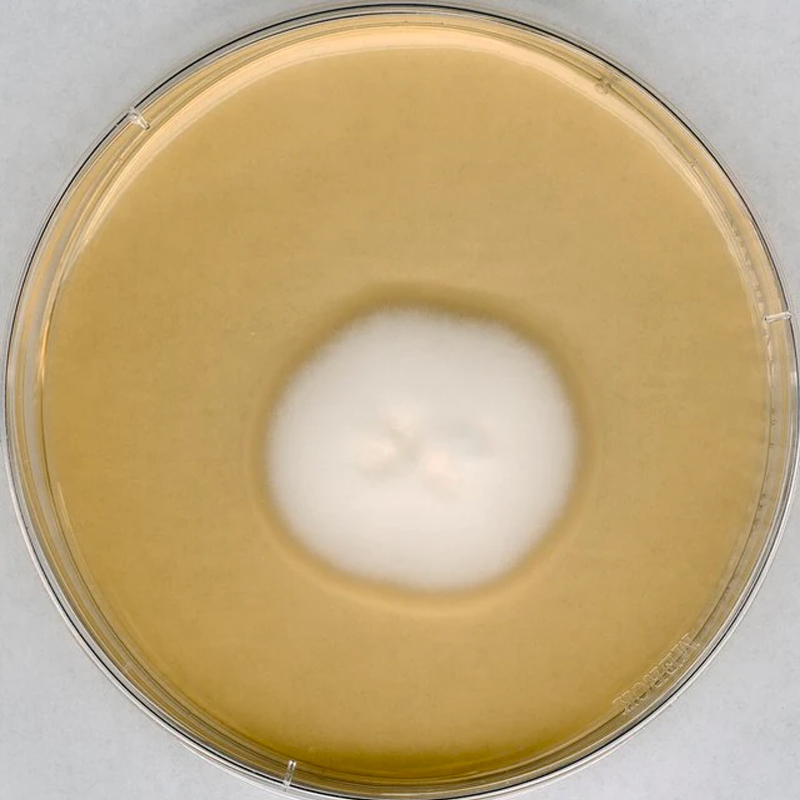
默克Merck GranuCult? 沙氏4%葡萄糖琼脂 1.05438.0500

热门关键词: 实验室仪器设备实验室分析仪器默克试剂实验室超纯水设备实验室培养箱设备

6T体育,体育资讯,体育赛事,健身训练,运动装备,体育直播,体育新闻版权所有 电话:400-0027-510邮 箱:[email protected] 公司地址:武汉市洪山区珞狮北路樱花大厦A座25层 传真:027-87660393备案号:鄂ICP备09021155号 技术支持:牛商网(股票代码:830770) 免责声明:因设计效果需要,网站有部分图片及图片字体引用网络,如有版权请联系删除
扫一扫!进入手机站
微信公众号